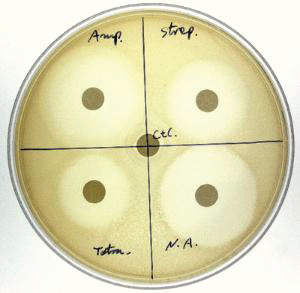

Antibiotic Sensitivity and Bacteria Activity Kit
Demonstrate the concepts of antibiotic selection, bacteria sensitivity and resistance, and applications for screening for antibiotic resistance with this handson kit. Students will determine which antibiotic is the most suitable to treat a bacterial infection by analyzing the inhibitory effects of antibiotics on selected bacteria
cells. Materials supplied for six groups of up to five students.